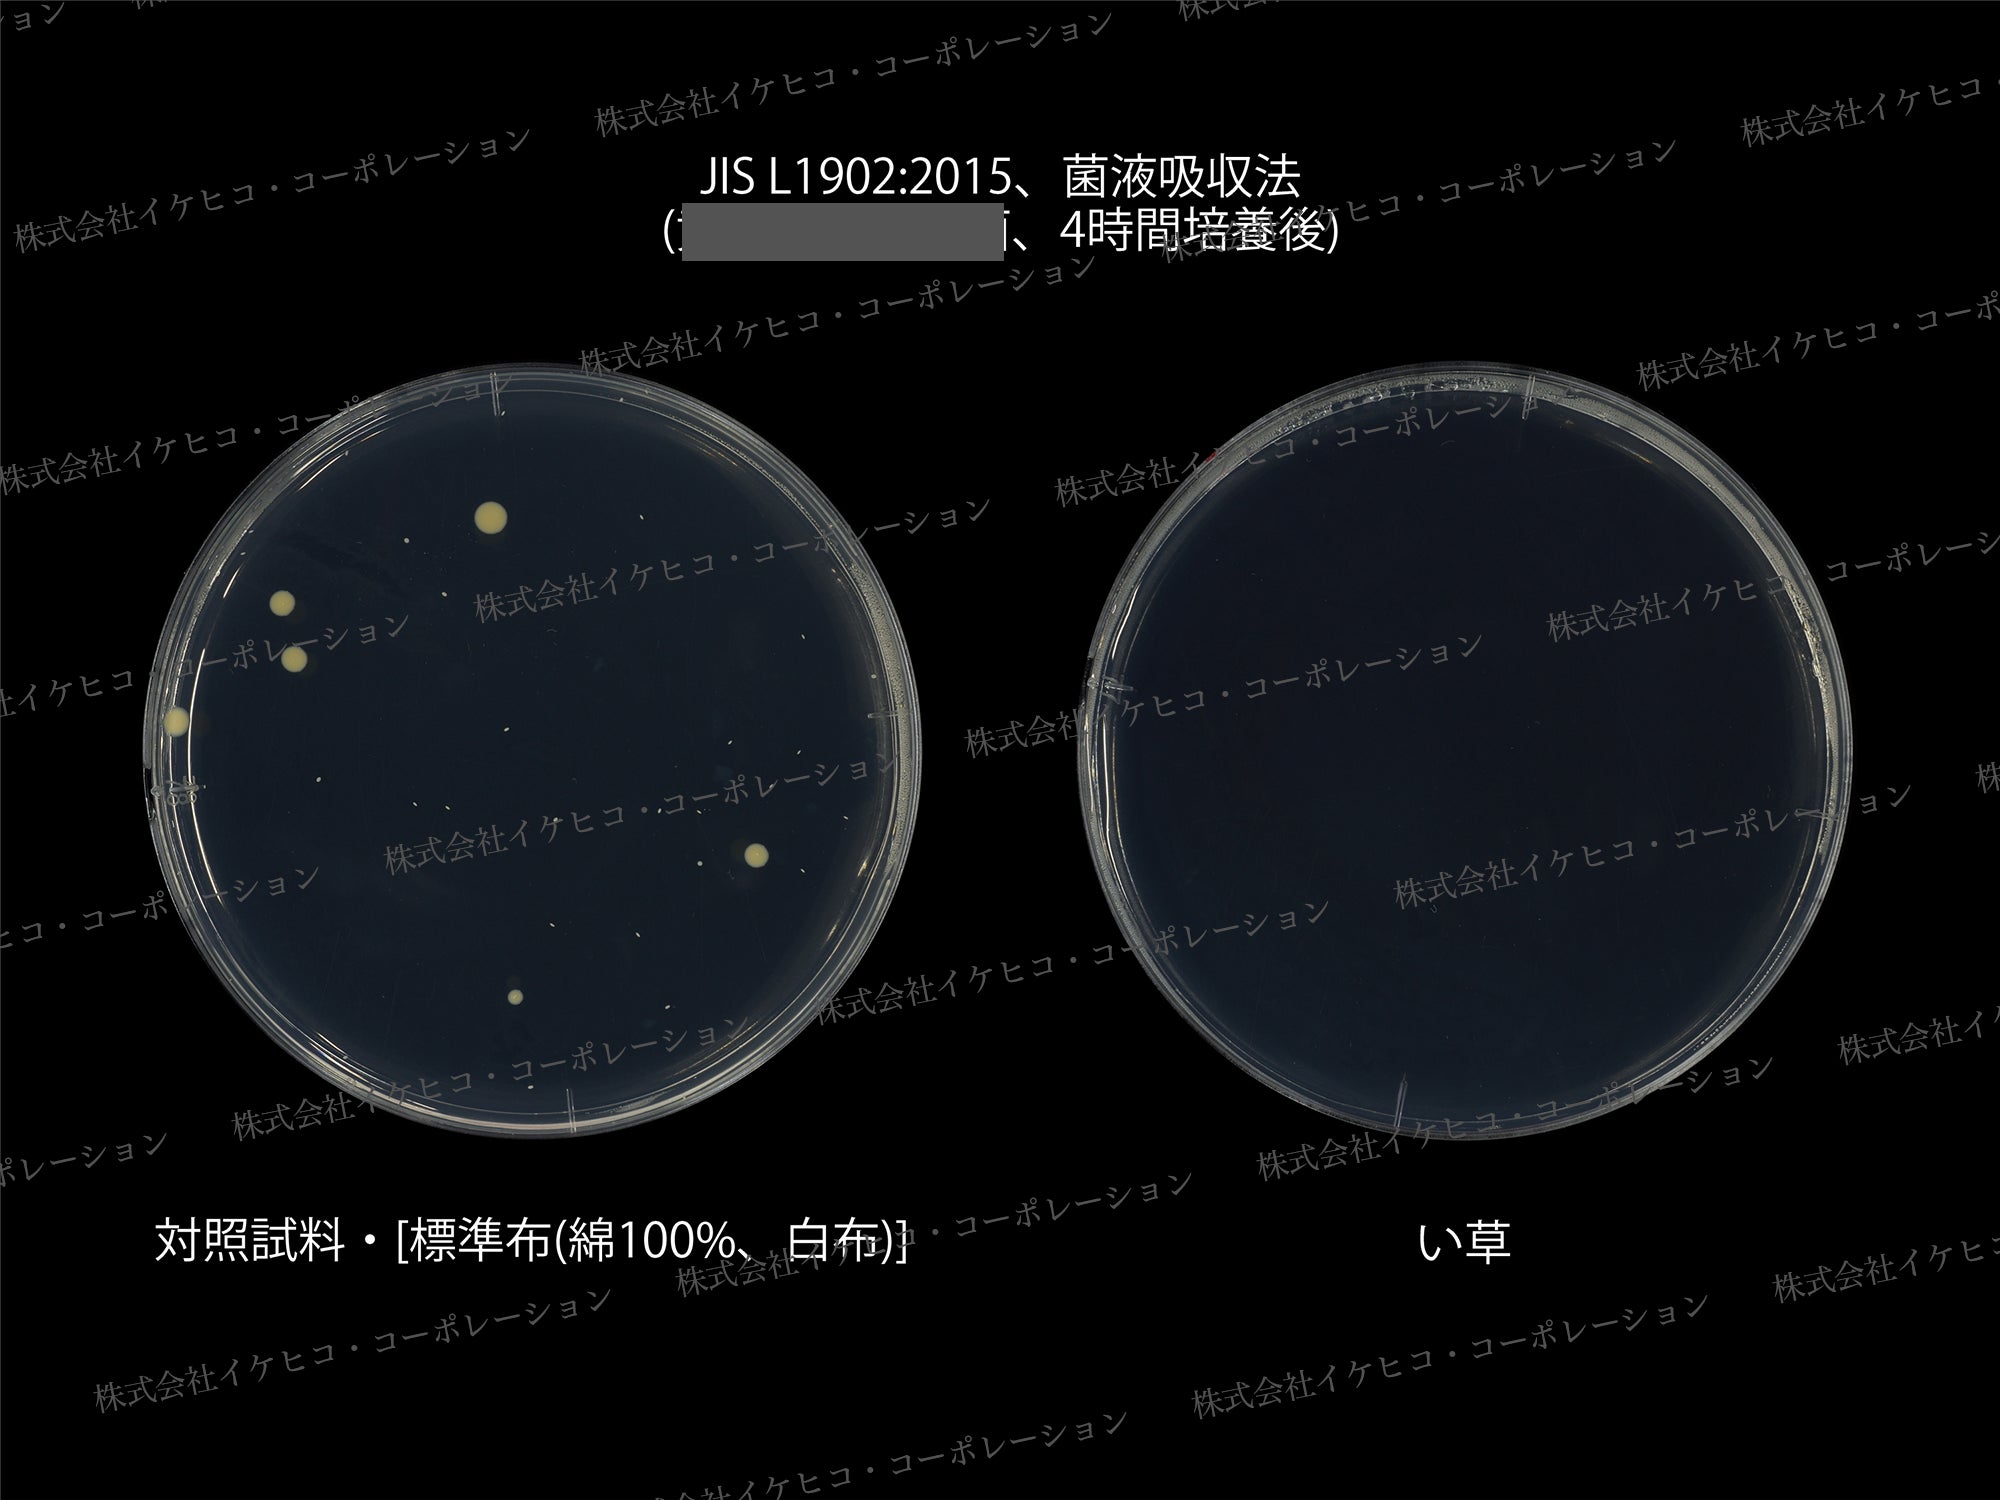
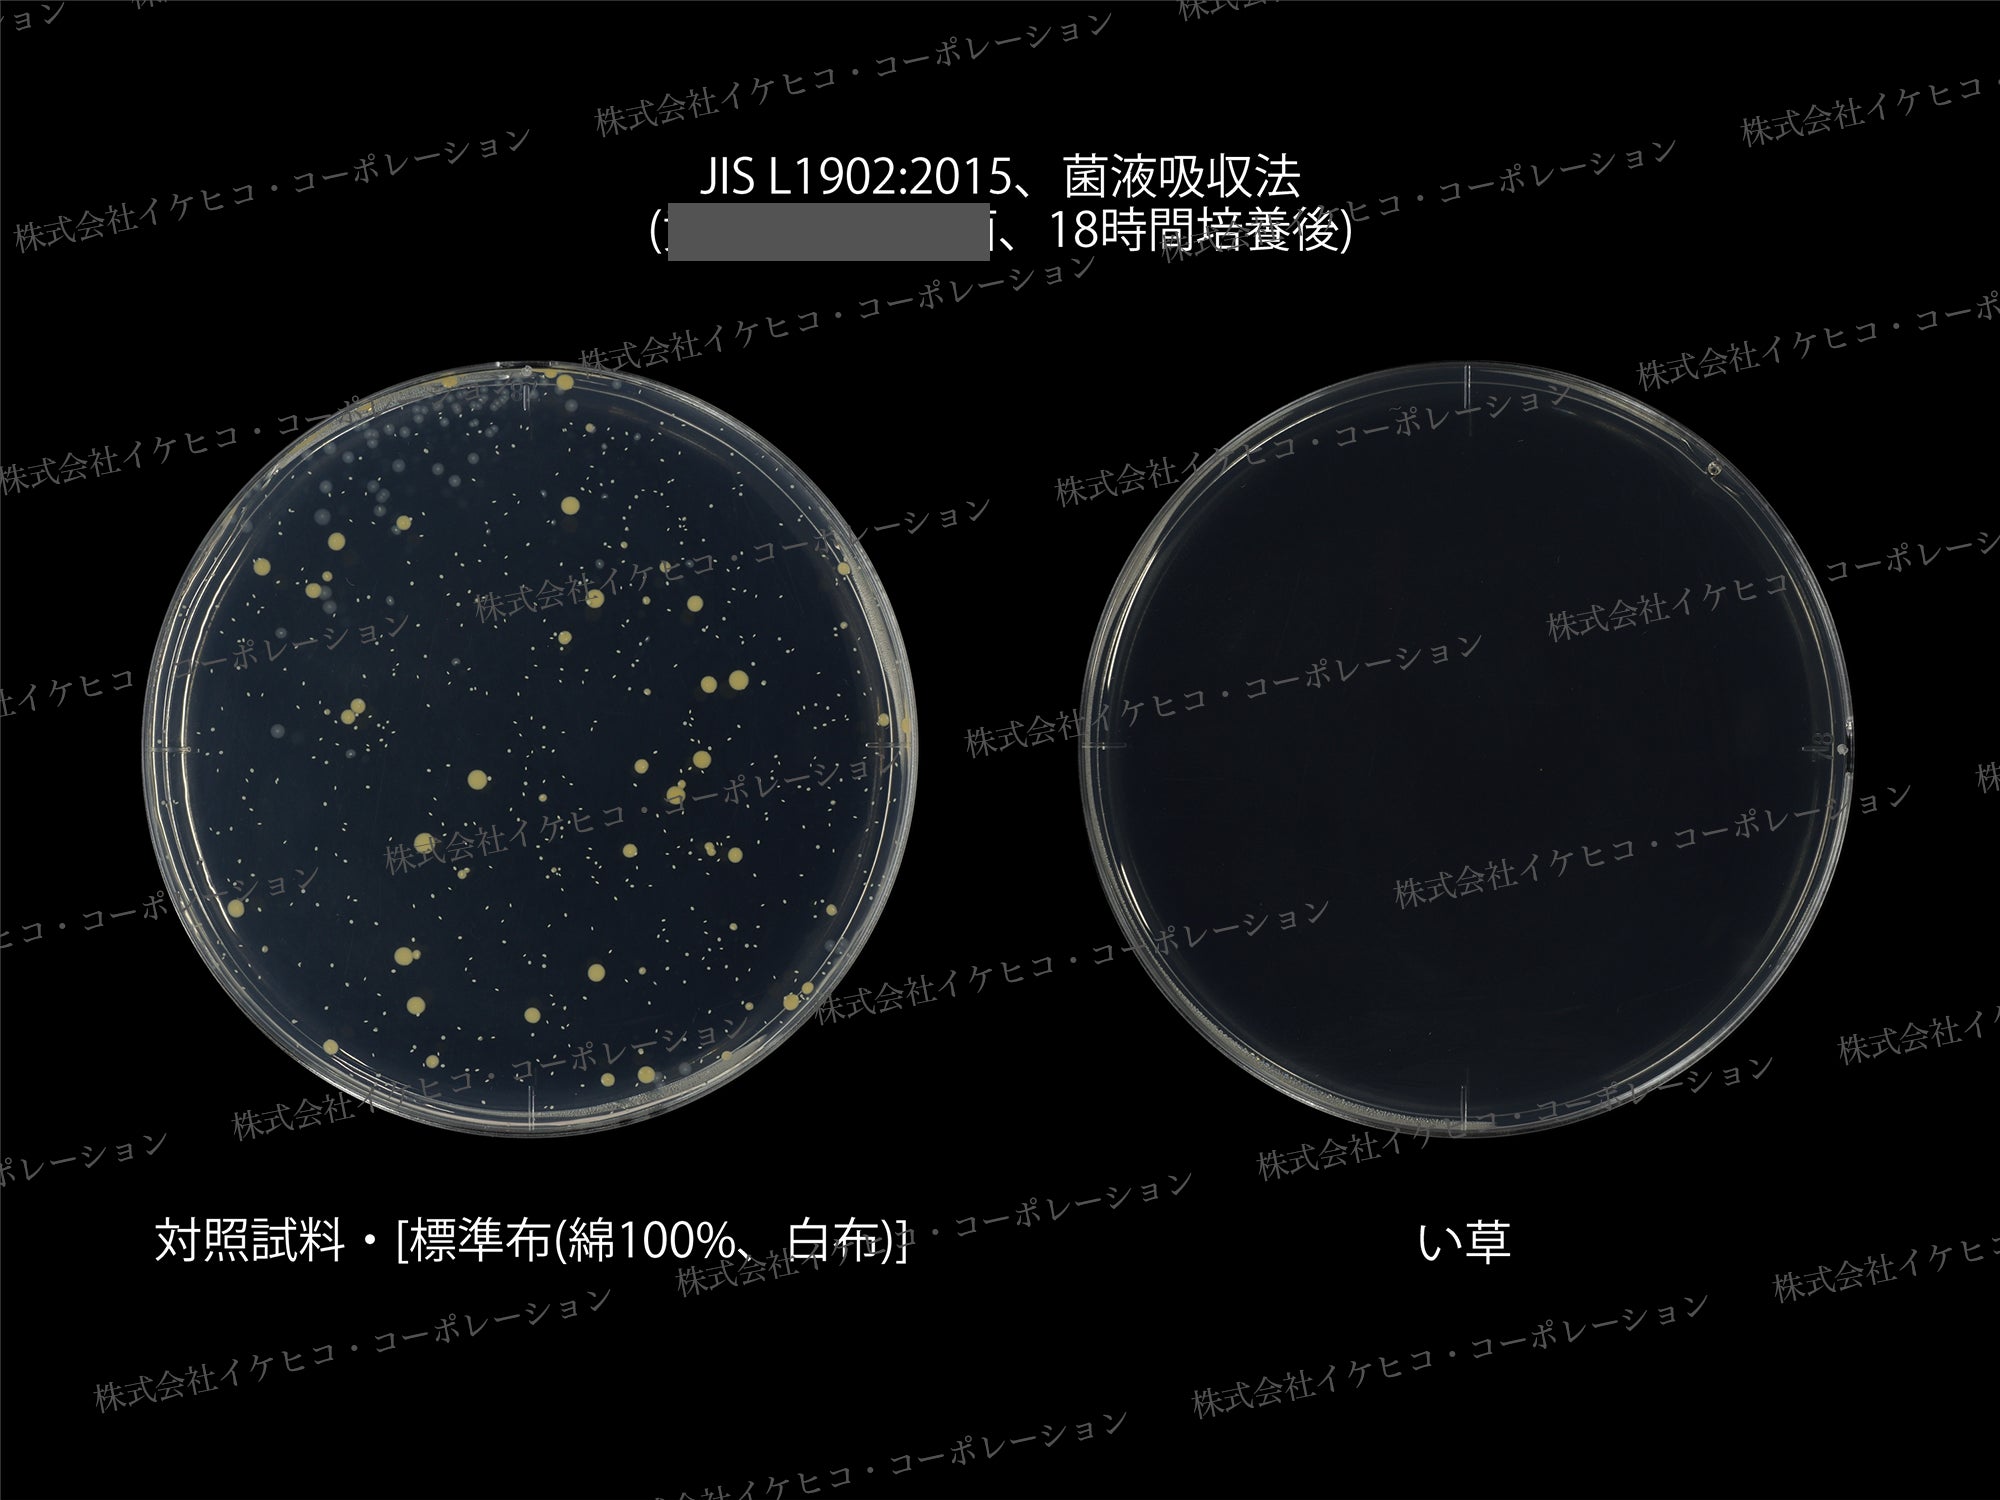

私たちは創業138年の福岡にあるインテリアメーカーです。machi-ya by CAMPFIRE発出展となる今回、国産のイ草(畳の原材料である植物)を使用したこだわりのインテリア「ミラクルシリーズ」で挑戦します!
日常には欠かせない「キッチンに立つ時間を少しでも快適に」をコンセプトに。表地には純国産の畳、裏地にはフィットネス用マットを使用した新感覚のキッチンマットを開発しました。
畳本来のクッション性+フィットネス用マットにより断然「足が疲れにくい」だけでなく、畳の効果で「洗濯不要で清潔を保てる」「素足がベタつかずサラサラ」「長年お使いいただける」製品となっております。


和室の畳と同じで洗わなくても清潔なんです。それは、い草に高い防汚性と抗菌防臭効果が備わっているから。経年によるイ草の色褪せで色は違いますが、目立った汚れは見当たりません!汚れが頑固な染みになっても、時間が経つと徐々に消えて、目立たなくなります。自然素材でこのパワーはすごいですよね。

醤油などの調味料もサッと一拭きでお掃除完了!こぼし染みもなく元通り。畳のキッチンマットだからこそできる拭くだけのカンタンお手入れです。い草の効果効能に関してはページ下部に記載してありますので、詳しくはそちらをご覧ください。
布のキッチンマットだと、マット自体を吸い上げて掃除機にくっついてきたり、めくれあがったり…。ロボット掃除機を使うと、ぐちゃぐちゃになったり…と、ちょっとしたストレスを感じる方も多いのではないでしょうか?

畳のキッチンマットなら、い草のサラサラ感で掃除機も引っかかることなく、スイスイ。更に今回の製品は、裏地が布やウレタンよりも重みのあるフィットネス用マットのため、吸いつきやズレなどのわずらわしさが格段に解消されています。

もちろんロボット掃除機もスイスイ動きます。

洗い物やお料理の際、汚れや水滴がキッチンマット外に飛び撥ねることも多々…。今回のミラクルキッチンマットは一般的なものよりも約15cmも長いので、広い範囲をカバーすることができます。大事な床を守ります!

裏が全面フィットネス用のマットのため、キッチンのどこに立っても足が疲れにくくなっています。主にヨガやトレーニングなどで使用するPVC(ポリ塩化ビニル)マットです。キッチンに立つ時間は長いので、足ラクでフッ軽に!

製品やい草のことについて詳しくご紹介していきます。

リターンのお品は3カラー(ブルー/ブラウン/ナチュラル)、3サイズ(約60×120cm/約60×180cm/約60×240cm)からお選びいただけます。

素材のままの無垢な無染土い草と、素材そのままを染めたい草を使用しています。もちろん九州産のい草です。粉っぽさも埃っぽさもなく、スベスベしています。無染土い草は自社栽培しています。
素足がベタつかずサラッとして、クッション性もある、最高な踏み心地です。

い草は植物ですが、素材のままに、高い防汚性と抗菌防臭効果があります。まさにミラクルな素材です。

い草本来のもつ機能のおかげで、洗わなくても清潔で、長年お使いいただけます。地球にもお財布にも優しいキッチンマットです。

小さなゴミも目詰まりすることなく、楽チンお手入れ!掃除機もロボット掃除機もスイスイ!
汚れが気になるときはサッとひと拭き!
▲ ナチュラル

▲ ブラウン
▲ ブルー
裏地は、ヨガやトレーニングなどで使われているフィットネスマットを採用しています。踏み心地もしっかりとしていて、足への負担を軽減します。少し重みがあるのでズレません。従来のい草キッチンマットは裏にウレタン素材を使っていたのですが、髪の毛や小さなゴミが絡まってしまうのが難点でした。
そこを解消したのが、今回のミラクルキッチンマット。水拭きも可能で格段とお掃除がラクになっています。※裏に粘着クリーナーを使用すると、表面が剥がれてしまうことがありますのでご注意ください。


従来のキッチンマットは45cm幅が多いのですが、このミラクルキッチンマットはなんと60cmの大判サイズ。何かと飛び散るキッチンの汚れからフローリングをしっかり守ります。
ヘリにも汚れにくい畳縁を使っています。洗わなくても清潔で長く愛用していただけるよう工夫を凝らしました。
▲ ナチュラル

▲ ブラウン

▲ ブルー


▲ ブルー/ブラウン/ナチュラルの3カラー展開

▲ 約60×120cm/約60×180cm/約60×240cmの3サイズ展開
日本の伝統的な小紋柄を細かな織りで表現しています。さらにどんなフローリングにも合わせやすい、ジャパンディスタイルの美しいグラデーションで仕上げています。ご家庭のキッチンに合わせてお選びください。どのカラーも自然な経年変化が楽しめます。
▲ 織りのデザインが際立つ無垢ナチュラル

▲ 落ち着きあるブラウンのグラデーション
このブラウンとベージュのグラデーションは、キッチンという空間において、様々なデザインや色彩とのなじみやすさを意識して色を付けました。キッチンに柔軟なインテリア性をもたらしたい方、落ち着いた雰囲気で他の色との組み合わせを楽しみたい方におすすめです。

▲ 涼し気なブルーの淡いグラデーション
キッチンに立って活動する際、何か考えごとをしたり、時間を意識しながら作業をしたり、心が穏やかな状態でないことってありますよね。このブルーのグラデーションで色付けされたデザインによって、落ち着きや冷静さをもたらし、心理的な効果がプラスに働くことを願ってこの色にしました。

▲ ナチュラル3サイズ俯瞰

▲ ブラウン3サイズ俯瞰

▲ ブルー3サイズ俯瞰
※画面上のカラーはご使用ブラウザやモニターの設定により、実物とは若干異なる場合がございます。
※また、い草は自然素材のため、1本1本風合いが異なる場合があります。い草ならではの自然素材ならではの魅力として、その風合いも経年による色の変化もお楽しみいただけると幸いです。

サポーターの皆さま、こんにちは。株式会社イケヒコ・コーポレーションの三上と申します。

い草という自然素材を使用することで、その香りや手触り感からもたらされる心地よさを感じていただき、

スーっと優しい気持ちになれることが、豊かな時間を過ごす一助になると考えています。

キッチンに立つ時間が、少しでもごきげんな時間になって欲しいという想いで、この製品をお届けいたします。

ぜひ応援いただけたら嬉しいです。


ライフスタイルの変化と共に目にする機会がめっきり減ってしまった、日本の伝統床材の畳。畳の原材料であるい草は、なんと1,400年もの歴史があり、絶えることなく消えることなく、現役で使われ続けている奇跡的な自然素材です。薬品使わず素材のままに、抗菌防臭・消臭・調湿・防汚など多くの機能が備わっています。


1. 抗菌防臭効果
2. 非常に高い防汚性
3. 消臭効果
7. 防火性も高く、燃えにくい
4. まるで森林浴のような良い香り
5. 空気もキレイにします
6. 湿度調整力


い草はニオイ菌をはじめとした菌の増殖を抑制します。ニオイの元が増えないので防臭効果も◎。薬品を使わず素材のままで、この効果!ミラクルな自然素材、い草です。
▲ 雑菌を培養して4時間経過のシャーレ
▲ 雑菌を培養して18時間経過のシャーレ
菌がじわじわと増えている布シャーレに対し、い草シャーレは菌が増えていません。高い抗菌効果がうかがえます。

い草は表面に油分を持っているので、非常に汚れにくい性質があります。判定4級以上で防汚性が表示できる繊維の試験で等級5の判定です!


嫌な生活臭の原因物質(アンモニア・酢酸・イソ吉草酸・インドール・トリメチルアミン・ノネナール・ビリジンなど)を吸着して減少させ、悪臭を軽減します。



なんとい草は自然素材なのに、防火性も高く、燃えにくいという性質も持ち合わせています。蚊取り線香を直にのせてもご覧の通り、燃え広がりません。


どこか懐かしいイ草の香り。個人差はありますが、畳のお部屋に入ると、あーいい匂いだなあと深呼吸したくなる方も多いのではないでしょうか。
これは畳の原材料であるイ草に、バニラの香り成分であるバニリンや、森林の香りであるフィトンチッドという芳香成分が含まれているからなんです。い草のキッチンマットを敷いたキッチン。ほんのり良い香りが漂って、日々の家事もちょっとした癒しタイムに。

い草の内部は六角形が重なったハチの巣のような構造で、その繊維と繊維の間には節があり、たくさんの小部屋を作っています。内部の表面積が広くスポンジ状になったい草が呼吸することで、空気中の二酸化窒素(HO2)やホルムアルデヒドを吸着し、室内の空気をきれいにしてくれます。

い草は非常に高い吸湿性を備え、乾燥時には蓄えた水分を室内に放出する特性を備えています。上に示した表からも、い草畳には優れた湿度調整機能があることがわかります。


い草製品の製造&販売を通じて、い草の栽培を増加させることで、CO2を削減(13:気候変動に具体的な対策を)し、持続可能な生産消費形態(12:つくる責任つかう責任)に貢献します。また、い草のニーズを増やしていくことで生産に携わる皆さまの待遇改善(8:働きがいも経済成長も)にも導いていきます。
畳や和室自体があるご家庭の方が少ない昨今。畳がイ草でできていることを知らない方も多いと思います。平成16年には1,260戸あったい草農家さんも令和4年には、約314戸と大幅に減少してしまいました。どうか皆さんに、この国産の高品質ない草を使ったインテリアを通じて、昔ながらの畳の良さ、い草の良さを感じていただけたら嬉しいです。

■ サイズ
60×120cm / 60×180cm / 60×240cm
■ カラー
ナチュラル / ブルー / ブラウン
■ 原産国
・日本
■ 組成
・表地:国産無染土い草
・ヘリ:無地畳縁(ポリプロピレン55%ポリエステル45%)
・裏地:PVC(ポリ塩化ビニル)5mm

Q:日ごろのお手入れはどうしたらいいですか?
A:い草商品を使用する場所は風通しの良い場所で、天気の良い日には窓を開けて常に換気を心掛けてください。お掃除は、い草の織り目に沿ってゴミを掃き出すか、掃除機をかけてください。週に1~2回、天気の良い日に日陰干しでカビの発生防止を行ってください。
Q:波打ちやシワが目立ちます。波打ちやシワは消えるのでしょうか?
A:はい、お使いになるうちにこれらのシワや波打ちは馴染みます。商品は流通上、折りたたんでいますので、お買い上げ・ご使用初めは多少の折りジワがあり、波打ったように見えることがあります。お使いになるうちにこれらのシワや波打ちは馴染みます。
Q:一部のい草に黒くなっているものが見られるんですけど…
A:い草は自然素材ですので、一本、一本に色差があります。商品は天然のい草を製品化したものなので、問題はありません。

2025年1月15日(水)10時 プロジェクト開始
▼
2025年2月28日(水)18時 プロジェクト終了
▼
2025年3月末までに配送予定

今回のリターンは60×120cm / 60×180cm / 60×240cmの3サイズ、ナチュラル / ブルー / ブラウンの4カラー展開です。とってもお得な超早割と早割があります。各リターン、少数の数量限定となっておりますので、お早めにお願いいたします。
リスク&チャレンジ
・製品の仕様は、一部変更になる可能性もございます。またい草は自然素材ですので、色や形状のバラつき、サイズ誤差などがあります。
・ご注文状況、使用部材の供給状況、製造工程上の都合等により出荷時期が遅れる場合があります。
・使用感などに関しては、感じ方に個人差が予想される製品でございます。そのため、使用感等に関する返品返金はお受けいたしかねます。
・雨の日などで濡れた場合は、カビの原因になりますので、風通しの良い場所で陰干ししてください。
※原則として、配送遅延に伴うご支援のキャンセルはできませんが、リターン配送予定月から1ヶ月を超えた場合には、希望者に限りキャンセルさせていただきます。
■ 特定商取引法に関する記載
●販売事業者名: 株式会社イケヒコ・コーポレーション
●代表者または通信販売に関する業務の責任者の氏名:猪口 耕成
●事業者の住所/所在地:〒830-0424 福岡県三潴郡大木町三八松1052
●事業者の連絡先:Tel: 0120-147-193 / Mail: support-fund@ikehiko.co.jp
●リターン価格:各リターン記載の通り *商品内容についてはリターン欄記載の通り※リターン価格とは別にCAMPFIRE(machi-ya)のシステム利用料として1支援毎に支援金額1万円未満の場合は250円(税込)/ 1万円以上の場合は支援額の2.5%(税込)が支援者様の負担となります。※上記システム利用料はCAMPFIREが受け取るもので、当社が受領するものではございません。
●送料:送料込み
●対価以外に必要な費用:プロジェクトページ、リターンに記載のとおり。
●支払い方法:CAMPFIREの決済手段に準ずる (詳細はこちら)
●引渡し時期: 各リターン詳細に記載の発送予定月を引き渡し時期とします。但し、開発・生産状況によって遅れが生じる場合がありますのでその際は当プロジェクトページ内の「活動報告」または購入者へのメール等で連絡します。
●キャンセル・返品: お客様都合による返品・交換・キャンセルはできませんのでご注意ください。
尚、製品到着後に破損や初期不良がある場合には交換させていただきますので「メッセージで意見や問い合わせを送る」から、または納品書記載の連絡先までお問い合わせください。
●その他記載事項:プロジェクトページ、リターン記載欄、共通記載欄(https://camp-fire.jp/legal)をご確認ください。
最新の活動報告
もっと見る
配送完了のお知らせ
2025/03/27 19:00みなさま、こんにちは。イケヒコ・コーポレーションの濵﨑です。本日、すべての製品の出荷が完了しました!今週末には皆さまのお手元に届く予定ですので、到着までもうしばらくお待ちください。また、一部の支援者さまには配送に関する確認のご連絡を差し上げております。個別にご案内しておりますので、ご対応のほどよろしくお願いいたします。画像は出荷作業の様子です!い草製品開発部のスタッフが、一つひとつ丁寧に梱包・発送を行いました。皆さまにお届けできる日を楽しみにしております!イケヒコ・コーポレーション 濵﨑 もっと見る【リターン配送について】応援ありがとうございました!
2025/03/24 15:48みなさま、こんにちは。イケヒコ・コーポレーションの濵﨑です。この度は、ミラクルキッチンマットのプロジェクトを応援いただき、本当にありがとうございました!みなさまの温かいご支援のおかげで、目標達成率860%を達成することができました。116人の支援者のみなさまには、感謝の気持ちでいっぱいです!商品が届いた際には、ぜひ使い心地や率直なご意見をお聞かせください。みなさまの声を次回の商品開発に活かしていきたいと思っていますので、どうぞよろしくお願いします!さて、リターンの配送状況についてご案内いたします。配送スケジュール●3/10(月) から順次配送を開始しております。●3/10(月)~3/26(水) まで、生産の進行にあわせて随時発送予定です。●3/28(金) までに配送完了予定ですが、万が一遅れが発生する場合は、活動レポートでお知らせいたします。配送に関するお願い●複数枚ご支援いただいた方は、色やサイズによって到着日が異なる場合がありますので、ご了承ください。●配送についてご不明な点がございましたら、お気軽にメッセージくださいませ。(1~2営業日以内にお返事いたします。)イケヒコ・コーポレーション 濵﨑 もっと見る
プロジェクト終了まで残り1日!
2025/02/27 10:00みなさま、こんにちは。イケヒコ・コーポレーションの濵﨑です。ミラクルキッチンマットのプロジェクトも、明日で終了します。応援コメント・お気に入り登録など、たくさんのご支援をいただき本当にありがとうございました!800%達成もみなさまのご支援のおかげです。重ねて御礼申し上げます。すべての配送完了予定は3月下旬を予定しております。配送開始日程につきましては、次回以降の活動報告にてご連絡いたします。現在は配送に向けて、ミラクルキッチンマットの生産中です!画像は生産の様子です。弊社で収穫したい草を使って、生地(畳表)を織っています。機械の両端にあるい草は、職人がい草を1本1本確認し、生地にムラが出ないように選別したものです。選別された良質ない草は、長さ・太さ・色・弾力性などを基準に厳しくチェックされています。職人が1本1本目で確かめることで、均一で美しい生地に仕上がります。実際にお使いいただき、生地のさらさらとした手触りや踏み心地、香りを感じていただけたら幸いです!ご使用後は感想やご意見をお聞かせいただければと思います。よろしくお願いいたします!イケヒコ・コーポレーション 濵﨑 もっと見る

















コメント
もっと見る